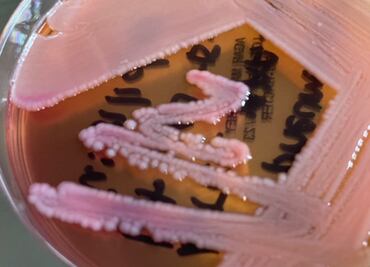
Estas son las bacterias más peligrosas del mundo: estudio

El abuso de estos medicamentos la favorece. Se estima que los productores de carne son responsables del consumo de aproximadamente 80% de los que se usan en todo el mundo

El abuso de estos medicamentos la favorece. Se estima que los productores de carne son responsables del consumo de aproximadamente 80% de los que se usan en todo el mundo

Se detectaron bacterias que se encuentran presentes en heces de humanos o animales, además que se contaminan durante el manejo para su venta y están sin refrigeración

Los investigadores analizaron por dos años muestras de queso que se venden en tres tianguis de la ciudad, donde encontraron la presencia de bacterias

Esto se desprende de una hipótesis formulada en 2003 por el neuroanatomista alemán Heiko Braak. Entre ellas sobresalen las del género Desulfovibrio

La Comisión Federal para la Protección contra Riesgos Sanitarios detectó 14 playas en seis estados que han rebasado el límite máximo de bacterias
Estos microorganismos fueron responsables de la muerte de más de un millón de personas en 2019

Hay distintas formas aceptadas para desinfectar tus alimentos, pero ninguna tan potente como esta fórmula que nos muestran en TikTok

Ya sea por descuido o por comodidad, dejar tu botella llena de agua dentro de un auto podría representar un riesgo tanto para tu salud como para tu automóvil

Es una práctica muy común pero llevar el celular al baño puede afectar el dispositivo y hasta causar problemas en tu salud

Por salud e higiene te decimos cada cuánto se recomienda cambiar la esponja para lavar los trastes